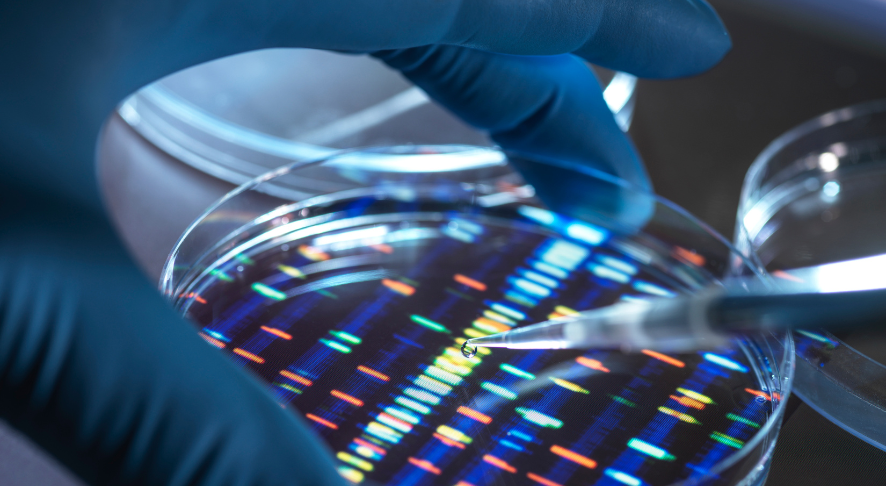

Myanmar Narrative
The IISS Strategic Dossier Turbulence in the Eastern Mediterranean surveys the geopolitical landscape, defence dynamics and energy prospects of the region spanning Cyprus, Egypt, Greece, Israel and the Occupied Palestinian Territories, Lebanon, Libya, Syria and Turkiye.
Ukraine’s ground-based air defence: evolution, resilience and pressure
Ukraine’s diverse air defence capabilities have demonstrated resilience against sustained Russian attacks. However, the combination...
The hidden costs of mass incarceration
Despite widespread implementation in Latin America, mass incarceration resulting from so-called mano dura policies has...
Obstacles to the India–Middle East–Europe Economic Corridor
The announcement of the new corridor looks more an achievement for public diplomacy than a...
Ukraine’s ground-based air defence: evolution, resilience and pressure
Ukraine’s diverse air defence capabilities have demonstrated resilience against sustained Russian attacks. However, the combination...
Global defence spending soars to new high
In response to rising threat perceptions, global defence spending rose to USD2.46 trillion in 2024...
Awaiting the ‘big bang’ in European defence
The EU Commission is making defence a top priority, with plans to create a European...
The Security Implications of Developments in Biotechnology
This report analyses the security implications of the developments that have taken place in recent...
Space Capabilities to Support Military Operations in the European Theatre
Individual European space capabilities are growing, focused on developing and strengthening national defence. However, efforts...
Russia’s ‘Shadow Fleet’ and Sanctions Evasion: What Is To Be Done?
The activities of Russia’s ‘shadow fleet’ are prompting governments to focus on how to crack...